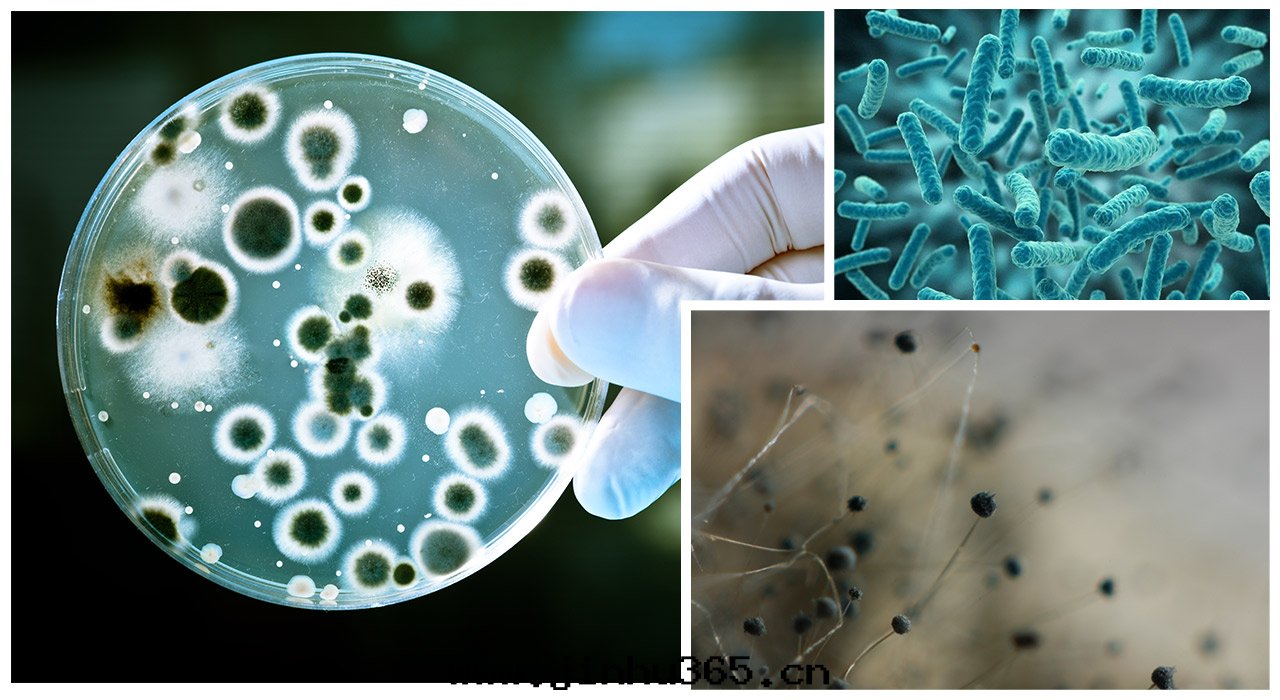

The first step to breaking through: Identify the biggest distractions
Basement space has unlimited potential, but before planning and designing, we should first consider the problems that may be encountered in the construction process:

For "underground", the most difficult thing to deal with is the dark and damp environment.
Waterproof is the most basic.
Water is a flowing liquid, can penetrate into all kinds of masonry, it has the characteristics of permeability, permeability and pressure.
But compared with waterproof, "moisture-proof" problem is obviously more difficult, once handled improperly, it is easy to grow mold.
The second step: find the right direction to force, twice the result with half the effort!
Q: Why do my paintings still get moldy when my home has "air conditioning" on all day?
"According to Harvard University research, in basement and adjacent space, moisture source: 70 percent from the structure, 30 percent from the air."
Air conditioning and dehumidifier only solve indoor air humidity, do not solve the structure humidity.
Based on this, do not cut off hidden dangers from the source. When the air conditioner and dehumidifier stop, peculiar smell will come out.
That's why we toss and turn, but we're never satisfied.
And air conditioning, dehumidifier operation cost is very high, very electricity.
Try to adjust the relative humidity of the air, did not think about changing the humidity of the structure, a little answer to the question.

Breaking the ice: Deconstruction - Reinvention - Renewal
Just because a problem isn't solved doesn't mean it's too difficult, it may just mean trying in the wrong direction. So the question is, right?

Q: How to change the humidity of the structure?
The concrete structure is like a spongy body filled with pores and water that can flow. EPT takes a different approach and aims to improve the waterproofing capability of the structure itself. Just as people get vaccinated in advance to boost their body's antibodies, they can avoid the disease once and for all.
Some traditional anti-permeability processes such as high pressure grouting, the use of stone tiles or multi-layer waterproof coating and other ways slow and passive, short effectiveness, easy to relapse, very low cost performance. Not to change the way of thinking to take the initiative is to go around in circles.
Tongqiang Technology "introduces electroosmotic pulse technology into ordinary people's homes, which is a more efficient way to inject a cardiac agent into the building body"
